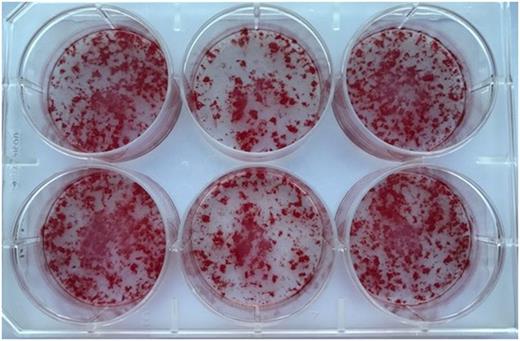
graphic

Abstract
Our laboratory has previously reported that Factor VIII (FVIII)-deficient mice have decreased skeletal health compared to their wild-type littermates. We also demonstrated a defect in growth and differentiation of osteoblasts derived from primary mesenchymal cells (MSCs) from FVIII-deficient mice. Osteoblasts, cells that build bone, are critical in bone remodeling along with osteoclasts, cells that resorb bone. Decreased osteoblast activity can explain our observations, but not the mechanism of how FVIII is involved. To further understand how FVIII affects osteoblasts in vivo, FVIII-deficient mice were given factor replacement before cells were isolated and cultured.
Methods:
10-12 week old FVIII-deficient male mice were given 100 U/kg doses of FVIII replacement at 24 and 4 hours before being euthanized and marrow isolated for MSCs. In addition, MSCs were isolated from wild-type and FVIII-deficient male mice without treatment. Cells were then plated in 6-well plates at 2.0x106 cells/cm2 in αMEM +1% antibiotic/antimycotic +10% FBS + 50 ug/ml ascorbic acid and 10mM β-glycerophosphate added to differentiate pre-osteoblasts into osteoblasts. Cells were cultured for 15-20 days at 37˚C with 5.0% CO2 with media collected every 3-4 days and replaced with fresh differentiation media. Media is collected and stored at -80°C for analysis on alkaline phosphatase activity in the cultures. Alkaline phosphatase activity was determined by the release of para-nitrophenol from para-nitrophenyl-phosphate spectrophotometrically. Mineralized osteoblast cultures are fixed and stained with a 4mM Alizarin Sodium Sulfonate which binds to calcium incorporated in the mineralized bone matrix. Reverse transcription-polymerase chain reaction (RT-PCR) is run on cDNA made from osteoblast RNA to look at markers of osteoblast function and signaling.
Results:
Replacing FVIII in FVIII-deficient mice restores osteoblast function and/or mineralization as seen in Figure 1. As alkaline phosphatase activity correlates to maturing osteoblasts, we see no differences at 5 and 8 days in culture; however, after 12 and 15 days of culture, FVIII-deficient cultures have more than 60% reduced alkaline phosphatase activity when compared to wild-type as well as the FVIII-deficient with FVIII replacement (p<0.05). There is no significant difference between the wild-type and the FVIII replacement cell culture in terms of alkaline phosphatase activity indicating FVIII treatment is important to osteoblast maturation and bone mineralization. Several bone markers were analyzed using RT-PCR, with the most significant differences seen in receptor activator of nuclear factor kappa-B ligand (RANKL) which is reduced in the FVIII-deficient osteoblast cultures that received FVIII replacement by 50% when compared to wild-type (p<0.03) and by 25% compared to FVIII with no treatment (p<0.003). RANKL is part of the signaling pathway between osteoblasts and osteoclast to activate osteoclast activity and is integral to bone remodeling and resorption.
Conclusion:
These results suggest that FVIII plays a direct role in osteoblast devlopment and help explain the mechanism of bone disease associated with hemophilia A.
Figure 1: Alizarin red stains for calcium deposits in cultured wild-type osteoblasts (Left), FVIII-deficient osteoblasts (Middle), FVIII-deficient osteoblasts with in vivo FVIII replacement (Right).
Taylor: Bioverativ: Consultancy, Research Funding; Janssen: Research Funding; Novo Nordisk: Research Funding; CSL Behring: Consultancy, Research Funding; Shire: Research Funding.
Author notes
Asterisk with author names denotes non-ASH members.